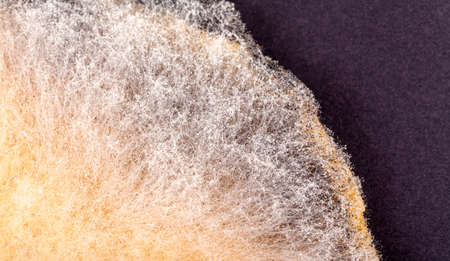

写真素材 - Moldy pancake surface, growing mold on food, common mould spores structure macro, extreme closeup. Mouldy food simple concept, nobody. Spoiled food products, way past expiration date, food going bad
作品情報
Moldy pancake surface, growing mold on food, common mould spores structure macro, extreme closeup. Mouldy food simple concept, nobody. Spoiled food products, way past expiration date, food going bad
- ID:176272482
- 作品種別:写真
- 作者名:Tomasz Śmigla
キーワード
- aged
- bad
- biological
- biology
- colony
- concept
- expiration date
- expired
- extreme closeup
- food
- from above
- fungal
- fungi
- fungus
- going bad
- gray
- growing
- growth
- macro
- microbiology
- mold
- moldy
- moldy food
- mould
- mouldy
- mouldy food
- natural
- nobody
- object
- old
- on top of
- organic
- organism
- pancake
- past
- product
- safety
- science
- simple
- spoilage
- spoiled
- spoiled food
- spores
- structure
- surface
- texture
- top view
- unhealthy
- up close
- white
類似作品
Ants macro aliv...
Mouldy bread on...
Closeup view fr...
surface of craf...
Tomato soup wit...
Acetic acid lea...
delicious home ...
Close up of mol...
Close up image ...
Round piece of ...
Mold Beautiful,...
Rotten bread on...
Macro picture o...
mango fruit pos...
Squid ink risot...
A close up of a...
green algae on ...
graffiti
toasted burned ...
old wall backgr...
Black and white...
Close up of Mol...
old beer cover ...
chemical waste ...
Traditional gri...
Round thin russ...
Mold on bread
Big old concret...
cake with almon...
microcosm: mold...
Penicillium mol...
a close up of a...
Mold on pita br...
Bread mold. Bea...
Mold growing ol...
a close up of a...
Pancakes from d...
dead leaf with ...
Air and oil bub...
Close up, macro...
The large mushr...
Bright colored ...
close up cookin...
Parasitic (Argu...
The bark of a t...
Topographic El ...
Closeup surface...
Close up of nat...
pancakes on a p...